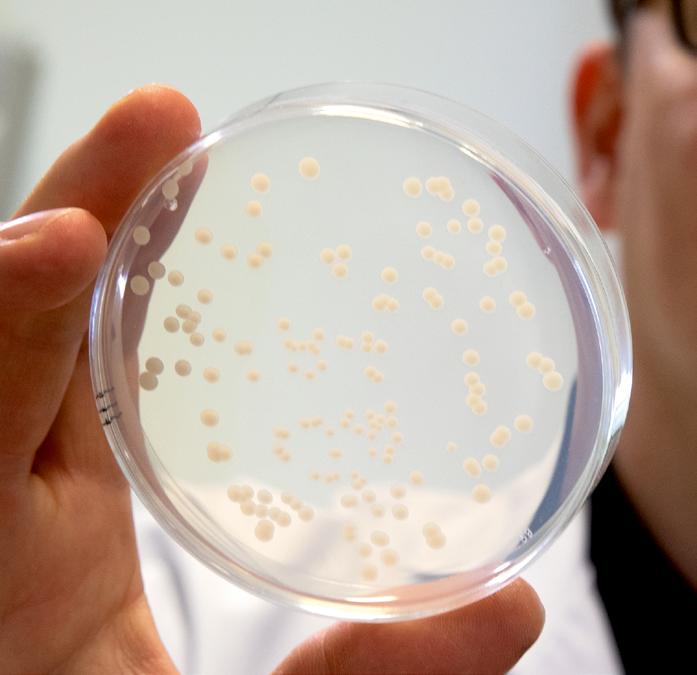

Martins:
5
12
6
9

27











Martins:
5
12
6
9

27






FAM STUMABO, a leading developer of industrial cutting machines, kicks off the new year with the introduction of Yuran Capcitec™, a high-capacity belt dicer for dicing and strip-cutting a variety of peppers and leafy vegetables.
Launched during the latest edition of Fruit Logistica, the Yuran Capcitec is engineered to meet the exacting needs of the frozen vegetable industry, which faces a tight processing window dictated by seasonal variations. The new dicer addresses this challenge by offering unparalleled reliability and durability, ensuring minimal downtime and maximum productivity.
Featuring a wider feed belt and optimised feeding method, the Yuran Capcitec delivers at least 30% extra feeding capacity compared to previous models. Its newly designed driven top belt guarantees precise product transfer and optimal guidance towards the cutting tools, resulting in superior cut quality and reduced product fracturing. The machine is engineered for cost-efficiency, with durable components that minimise maintenance expenses and downtime. Its splined shaft system facilitates easy tool conversion, enhancing inspection and cleaning processes.
The Yuran Capcitec is suitable for peppers and leafy-type green vegetables, like bell peppers or capsicum, capia, jalapeño and chili peppers, as well as raw or blanched greens such as spinach, radish, kale, cabbage, and mustard leaves. Other popular products are raw or brined citrus peel and a variety of herbs such as parsley.
www.fam-stumabo.com
Over 1,200 exhibitors are set to come together this April as Food & Drink Expo returns to the NEC, Birmingham alongside The Restaurant Show, Farm Shop & Deli Show, National Convenience Show and The Forecourt Show as part of the 2024 UK Food & Drink Shows (29th April – 1st May).
Providing the most direct route to the UK food and drink market and bringing together the very best in product innovation, business advice and operational insight, Food & Drink Expo is a festival of grocery, foodservice, manufacturing and speciality retail offering visitors a unique perspective across three days.
Visitors can expect to see an unparalleled range of products and services as big name exhibitors, small scale innovators and technical solutions fill the show floor. Those exhibiting include: Belvoir Farm Drinks (Stand T238),

olive oil brand Filippo Berio UK (Stand S219), The Tofoo Co. (Stand DD251, Camelot Chilled Foods (Stand DD248), Meadowvale Foods Ltd (Stand Z229), chilled packaging providers Icertech (Stand V230) and NielsenIQ (Stand D259).
For the full list of exhibitors and products on show, visit: www.foodanddrinkexpo.co.uk
Standalone off-line coding systems, or feeders, are ideal for printing date or batch information onto packaging sleeves – providing flexibility and accuracy where needed.
Within our range of feeding systems, we have two that are ideal for the reliable handling and coding of sleeves: the RF Lite and the RF Auto. Both take a flat-form sleeve from a stack and pass it underneath a printer or labeller to be coded, before returning the marked sleeve to another stack, ready for operator removal. The suitability of the system much depends on the dimensions of the product, desired print, and the expected throughput.
The RF Lite is our entry-level system, ideal for those looking to move away from manually coding their sleeves. Its small footprint makes it easy to fit into tight production spaces and it can be supplied with a wheeled stand if it’s intended to serve multiple lines. It is fitted with a clean, maintenance-free thermal inkjet printer as standard, to ensure crisp, consistent prints.

The RF Auto is a heavy-duty feeding system, ideal for running high volumes of product. It benefits from an auto-gating system, which allows it to automatically adjust to handle products of varying thicknesses, such as windowed or lift-the-flap sleeves. It can accommodate a variety of coding and labelling technologies to suit the application.
For more information on our feeding systems or how you could benefit from coding your sleeves off-line, contact our friendly experts today!
https://rotechmachines.com/company/contact-us
Gong cha England and Redcat have announced that the fast-growing bubble tea chain will use Redcat’s hospitality IT platform to underpin ambitious plans for UK expansion.
Serving a range of authentic hot and cold teas containing its signature ‘bubble’ tapioca pearls, Gong cha operates 2,100 stores around the world and intends to grow significantly in the UK. It sees the opportunity to expand from its current 12 UK stores, to 16 by the end of 2024 and has an ambitious longterm goal of reaching 500 stores.
Partnering with Redcat, Gong cha England – the trading name of master England franchisee GC Tea Ltd – will have a suite of digital services to enhance customer experience & run operations effectively across current and future stores. Through one integrated platform, Gong cha England will use Redcat’s point of sale (POS), self-service kiosk, loyalty program, mobile app, online ordering, and integration with Just Eat, Uber Eats, and Deliveroo. Future plans include adding Uber Direct and ordering food with Google. Providing real-time visibility of their whole business,

the Redcat IT platform will give Gong cha England the ability to manage menus across multiple consumer channels, and deliver a loyalty programme that works across in-store POS, online ordering and kiosks.
Bobby Sidhu, General Manager of Gong cha England, said, “Having the right IT platform, one that integrates all functions into a single system, is critical to managing a business efficiently & building the loyalty and customer retention that fuels growth. Redcat provides a seamless full stack solution, designed for restaurants, and which fully matches our ambition.”
www.gong-cha.co.uk
www.redcat.technology
Chinese cuisine has been a staple of the UK food scene for many decades, with its quintessential flavours. From Chinatowns across many major cities, to restaurants, to the influence of international Emmy nominated, award-winning chef Ching-He-Huang MBE, Chinese food is here to stay.
At the heart of all authentic Chinese cooking is carefully selected spices and seasonings, each lovingly added to give distinctive flavour fusions.

The Southwest region of China has a distinctly, warmer climate and is known affectionately as the ‘land of abundance’. The local chillies and Sichuan peppercorns in particular give flavoursome kicks.
But what if you could bottle this in authentic UK condiments?
Founder of award-winning Yep Kitchen, Tom Palmer spent ten years living in Beijing and during the long summer months, would travel down to the Southwest region, to enjoy the warmer climate and regional food delights. He fell in love with the cuisine from this area and on return to the UK decided to produce Southwest Chinese condiments.
“It was the best way of paying homage to my adopted country. Although the UK food scene was flooded with Chinese cooking and flavours, condiments using Southwest ingredients are still a niche area,” Tom explained.


Before leaving China, Tom had formed relationships with suppliers before his targeted soft launch. During the ‘development phrase’ as Tom calls it, the condiment range was tweaked, the website was built and stylised eyecatching artwork was designed for the product labels. During the summer of 2023, the products were ready to launch to the retail sector, including high-end outlets like Selfridge’s & Co and Panzer’s Deli.

“We have always been a big hit at festivals and events, especially our weekly farmers’ market at Victoria Park, with customers remarking on our unique product line and artistic labels. We have a wholesaler who looks after 80% of our retail market and individuals can buy off our website.”
Tell me more about this award-winning condiment range
This unique crafted range comes in four delicious flavours:
● Sichuan Chilli Crisp
● Garlic Chilli Oil with Beef
● Hunan Salted Chillies
● Garlic Chilli Oil
Tom and his team import dried Erjingtiao chillies and Sichuan peppercorn from the Southwest region from local growers and hand craft small batches of finished products from their shared New Covent Garden kitchen.
Each of the four flavours are designed for marinading, cooking, mixing and drizzling, for a true taste sensation.
“SME News awarded our range as the ‘Best Chinese Condiment Brand’ in 2022 but it didn’t stop there.
“Our Sichuan Chilli Crisp and Garlic Chilli Oil with Beef flavours both scooped up two-Star Great Taste Awards in 2023, which was sensational for our new company.”


What’s next for Yep Kitchen?
At the end of April, the team will be moving to a larger kitchen premises in West London, to expand the business further. Yep Kitchen started out as a cottage industry, working in a shared kitchen space with access to commercial kitchen equipment.
“Mission Kitchen has been the perfect platform for us to grow and reach a point where we’re ready to take on our own space and expand our production. We are asking our existing and new customers to help us reach our final target of

£15,000 to crowdfund our new premises. We have an exciting range of products we can send customers, for example, for a £15 pledge, we will send two of our delicious chilli oils with free delivery as a thank you. Giving you some welldeserved discounts for supporting our expansion!
“Looking to the future, we have plans for exciting new flavours & increased distribution, spreading our products even further!”
As we enter the auspicious Year of the Dragon, we want to wish Tom and the team at Yep Kitchen luck and wisdom for continued Chinese culinary innovation and creativity.
Yep Kitchen will be at the BBC Good Food Show Winter 2024 in November and Taste of London 2024 in June.
www.yepkitchen.com

Want to take your business to the next level? Plant Based World Expo Europe is the only 100% plant-based expo for retail and foodservice and the 2023 show, held at London’s ExCeL from 15-16 November, did not disappoint!
Whether you’re looking to improve your profitability, find menu items that capture customers, or implement long-lasting changes that will transform your business as well as the global food system, then Plant Based World Expo makes it all possible.
As well as being the launching platform for hundreds of new brands and showcasing the latest industry trends, findings, knowledge and products, the 2023 show welcomed a large range of exhibitors all striving to move the plant-based scene forward.
Previous attendees include Harrods, Tesco, Sainsbury’s, Papa Johns, and Wholefoods
Market. The expo is known to have attracted some big well-known buyers all looking for that one unique, innovative idea and product.
We have selected some of our Top Exhibitors from the show whose products positively contribute towards the growth of the plantbased industry. These include: Alzchem Trostberg, an international chemical company that has positioned itself in the world of specialty chemistry with both well established and new products for global markets. Dodoni SA, the developers of the delicious free of dairy and rich in taste Greek White plant-based feta. EVE Vegan, an independent certification body working to build a more respectful future for all animals.
Isauki Superfoods, a plant-based seafood brand with a mission to make plant-based seafood more mainstream. More Alternative Foods, the creators of delicious pumpkin seed meat. Le Grand Bluff, the creators of the infinite vegan foie gras and other various plant-based alternatives with
More Alternative Foods Ltd, a leading innovator in plant-based products, is thrilled to announce a strategic partnership with a new distributor in the Netherlands Green Pro International. This collaboration marks a significant step in our commitment to making our delicious pumpkin seed meat accessible globally.

Green Pro will enhance our reach, ensuring our delicious and sustainable plantbased products are readily available to businesses and consumers throughout the Netherlands.
delicious plant-based choices appealing to everyone.
About More
Alternative Foods Ltd
More Foods creates delicious and meaty products utilising pumpkin and sunflower seeds as protein sources. Our products are cleanlabel, have a short ingredient list, and contain no major allergens. We offer a variety of cuts which can be incorporated into any menu.

More Foods remains dedicated to providing nutritious, clean-label products that do not compromise taste and sustainability. We look forward to a successful partnership that aligns with our mission of making

More Foods uses side streams from the seed oil industry to create hearty proteinpacked, plantbased ingredients. Committed to promoting a healthier and more sustainable world, More Foods strives to make plant-based choices attractive to all.
For more information, visit: www.more-foods.co
a French twist. Ragood, Italian plant-based handcrafted ready sauces and soups. Rival Foods, the innovative plant-based startup revolutionising the food industry with delicious and sustainable meat alternatives. And of course, Sheese, bringing an award-winning portfolio of dairy free cheeses made on the Isle of Bute.
The conference line-up included talks from academics, institutions, innovators, retailers, award-winning activists, entrepreneurs and investors, as well as some of the best-known journalists and broadcasters in the food and drink industry.

The show also featured Veganuary’s 10th anniversary global film premiere, leadership addresses, and panels focussing on collective challenges affecting the UK’s vegan food industry. Just some of the talks were on How Brands can Navigate Foodservice for Long-Term Success, A Pragmatic Look at the MeatAlternative Market and Where it Could Go, Changing the Culture of Food on University Menus, and many more.
Tickets for this year’s show, back at London’s ExCeL from 13-14 November 2024, are available now.
https://plantbasedworldeurope.com/
AtBute Island Foods we want to help our customers develop their menu’s to create enticing and tasty plant based meals for those choosing this option.
Our consumer understanding has taught us that consumers feel eating a plant-based meal is a perfectly normal thing to do, but they find that menus don’t always feel inclusive, leaving them feeling frustrated, often with a single plant based option apologetically placed in the corner of a menu.


We want to change this, and with the versatility of Bute Island’s Sheese or the Cheddar’ness of Cathedral City Plant based, there is the opportunity to use one or two products to make dozens of high quality delicious cheesy plantbased meals.
We’re at an exciting juncture where our recipes are developing quickly to close the gap to dairy.
The melt, provides oozing, bubbling taste cues, and the flavours give you the freedom to make anything from Toasties to Pizzas, Lasagnes to Dauphinoise’s, and even sweet treats like Cheesecake.
Bute Island Foods is part of Saputo and we showcased our delicious and versatile plant based options in Panini’s at the Plant Based Expo in November last year. We were blown away by the positive response and acknowledgement that now was the time to put Plantbased Diary-Free products firmly on the menu. We’re have two fantastic leading brands in our portfolio, with strong availability across the trade, and look forward to supporting our customers in making superb, tasty plantbased foods for their menus and delighting their customers.
Customer Services:
T 01700 505357
Bif.orders@saputo.com
For 60 years, DODONI has been Greece’s first choice for authentic Greek feta. Over the decades, our artisan cheese and yoghurt makers have learned exactly what makes our food so tasty.

Now, we proudly offer the DODONI Plant’d range – a delicious vegan alternative to our much-loved dairy products. So you can enjoy all of the same quality and flavour of DODONI, in plant-based perfection.
Our DODONI Plant’d Greek White is made from coconut oil for an authentically creamy texture. And because of our time-honoured methods, just like our classic Greek Feta, you can guarantee the same rich DODONI taste.
As for our DODONI Plant’d Greek Pots, they
are made with oats and live vegan cultures for a deliciously thick and creamy plant-based alternative to yoghurt. Packed with flavour, these pots are perfect for breakfast on-the-go, as well as an indulgent afternoon snack.
Available in natural flavour – just like our authentic Greek Yoghurt – or in delicious flavours like warming Apple-Cinnamon, creamy Vanilla, and zesty Orange-Bergamot.
Whether you’re a vegan, vegetarian, or simply looking to explore new culinary horizons, our plant-based offering is perfect for everyone!
T +30 231 600 1690 export@dodoni.eu https://dodoni.com/

Creatine, a body own substance, plays an important role in the energy metabolism of the body. It is well known in sports, but because of its positive impact on cellular energy metabolism, there is an increasing number of applications as a general dietary supplement. These effects are scientifically well-researched and supported by two EU Health Claims. While creatine is endogenously produced, creatine from food completes the availability for the body. Since Creatine is only found in animal based products, especially plant based diets benefit from Creatine fortification. Additionally, creatine plays a role in the biosynthesis of proteins, making it a perfect addition to high-protein products such as yogurts or vegan alternatives
Experts agree that creatine has the potential to become the next mega-trend in modern

Rival Foods stands out as a pioneering Dutch FoodTech startup, dedicated to crafting innovative plant-based meat alternatives. Our diverse product range includes Chicken Filet, Tenderloin, Pulled Pork and Chicken, as well as several other innovations just as our Fish Filet that are currently under development.
What truly sets our creations apart is the unique
nutrition.
For this reason, Alzchem has introduced Creavitalis®, which is creatine monohydrate especially tailored for the food industry.
Creavitalis® is 100% Made in Germany and is produced under the highest quality and sustainability standards. It is Halal, Kosher, and free from all animal components and therefore perfectly suitable for a meat reduced/less diet.
To ensure the best and purest product, it is essential to look for one of the two quality seals (Creapure® or Creavitalis®) on products. Further information on this topic can be found at: www.creatineforhealth.com and www.creatine.global

In just five years, EVE Vegan certification mark has skyrocketed to prominence in the vegan certification realm. Its rapid rise reflects the growing demand for transparency in consumer goods. Partnering with major brands in over 25 countries, EVE Vegan offers a seal of integrity and sustainability, appealing to both vegans and non-vegans alike.
Behind EVE Vegan is a deep philosophy of driving innovation and change. Between manufacturing technology and raw materials, EVE Vegan push certification one step beyond. Now the most reliable vegan certification ever on the market, with values solid as a neutron star.
At the core of EVE Vegan’s innovation is a commitment to pushing boundaries and challenging the status quo. By proudly displaying the EVE Vegan certification, brands signal to consumers that they’re not just selling a product; they’re championing a cause.
www.certification-vegan.org
whole-muscle fibrous texture, which is created through our patented production process called ‘Shear Cell Technology’. Therefore, the entire production only requires up to seven natural ingredients without any added E-numbers. As a result, our products are not only sustainable but, more importantly, packed with healthy nutrients, & a similar amount of protein as meat-based products.
Our business model focuses primarily on partnerships with gastronomy companies in order to incorporate our products into the menus of restaurants and catering companies. In addition to its unique texture and healthy ingredients, the versatile taste of our products makes a suitable choice for a variety of cuisines and diets. Our exclusive focus on commercial partnerships allows us to tailor our services to meet the specific needs of our partners and therefore deliver the highest quality.
Interested? Please contact our sales team at: sales@rival-foods.com


Boasting a high nutritional content that is mainly based on micro and macro algae, Isauki Foods is an innovative, start-up plant-based brand with food products that are designed to offer healthy and sustainable alternatives to seafood.
Isauki Foods proved an extremely popular exhibitor at last year’s Plant Based World Expo 2023. From Stand K8, the Spanish brand did feel that an economic slow-down was present at the event, but this did not stop the team from showcasing some of their best plant-based products that blew customers minds.
“These are not shrimps”, “These are not squid rings” and “These are not baby eels” are all products by Isauki Foods. Unbelievably, the company has managed to create the same texture and flavour as normal seafood products, but with the added bonus of living a cruelty-free life.
There is nothing fishy about Isauki Foods products! Using natural ingredients such as legumes, cereals and vegetable proteins, as well as different applications of the fascinating world of algae to create 100% plantbased, healthy and delicious products. They also deliver highly-nutritional

content such as meeting your Omega 3 and Vitamin B12 intake, suitable for pregnant women, and a great form of calcium, iron, vitamin D, magnesium and protein.
The growth of plant-based seafood has just started and it’s a fact that it’s increasing year by year. We have found out a vast change in consumer buying habits such as the beginning of the introduction of plant-based diets into people’s lives.
If you are interested in selling Isauki, get in touch below: hello@isauki.com www.isauki.com
Creating the food of tomorrow, Le Grand Buff which when translated into English means The Grand Buff, is a French company that has taken on the bold challenge of reinventing the classics of French gastronomy in a 100% plant-based and organic way.
Le Grand Buff had visitors mesmerised when tasting its innovative plant-based products at last years Plant-Based World Expo Europe. Its present range includes fascinating vegan alternatives to Foie Gras, Pâté, and Vegetable and Organic Terrines, all of which embody the perfect marriage between refinement and compassion.
its products and works to create a wholesome environment that brings people together, uniting animals and humans on a level playing field.
Le Grand Buff represents so much more than just plant-based products. It works to create change and drive the plant-based revolution forward without ever harming animal welfare. This hard work has resulted in great tasting food that delivers all the non-guilty pleasures of gluttony.
Ragood is a young Italian company in love with both its culinary traditions and sustainability. We handcraft our ready-made sauces in compliance with the best Italian recipes and offer typical preserves using only plant-based meat and vegetable products.
We work with new food technologies and cutting-edge machinery to offer an innovative but equally tasty product to surprise the most sceptical person.
We stand out for our craftsmanship and quality of traditional readymade vegetable sauces as we use prepared and complete meat alternatives rather than simple granulated based on legumes, tofu, or soy. Anyone who tries Ragood doesn’t notice the difference and instead enjoys a tantalising mouthwatering experience crammed full of goodness.
We use only Italian tomatoes to reproduce the texture and taste of classic Bolognese. We have also added porcini mushroom ragù,

Sicilian ragù, mixed vegetables, and pepper ragù to our range to guarantee a wider choice without compromises. Our motto is “Same taste, different philosophy!”
Our goal is to provide the flexitarian and vegan market with ready-made gluten-free and lactosefree, sustainable sauces that ‘meat’ the needs of all consumers.
Ragood is an Italian company aware that small daily choices must be guided by the commitment to a sustainable future and innovation because they affect the lives of all living beings. And if this is possible while enjoying a good pasta Bolognese, why not?
T +39 08118207536 ciao@ragood.it


Offering a bite of luxury, these products offer an unusual authenticity that derives from its very own traditional high-quality French terroirs. Le Grand Buff is proud of
Indulge in some Vegetable Forest Terrine or enjoy some Fou Gras with Black Truffle, or even delight yourself in an old childhood favourite, Basque Pâté with the subtle taste of Espelette pepper to be enjoyed on lightly grilled toast or accompanied by a vegetable pickle or pickle.
legrandbluff@gmail.com www.legrandbluff.com

Founded in Paris in 2019, Bek & Veggie is a young company with an objective to produce best quality organic foods. Our first and main product is our unbeatable Almond drink.
We offer the best taste of Almond drink on the market using only 2 ingredients (Almonds & Dates) or only Almonds & Water with no additives.
Our homemade style Almond milk drink is 100% organic and rich in protein and essential nutrients.
We have a higher concentration of Almonds – 17% and 5% of Dates.
With us, you experience the cleanest version of all nut milks.
www.bekandveggie.com

The art of fermentation has a long history and is enjoying renewed popularity today. It’s the foundation of many of our favourite foods such as cheese, beer and bread. In the field of bread baking BÖCKER has played an important role since 1910, as an expert in sourdough and fermentation.
While the use of sourdough in baked goods is well known, the use of fermentation processes with lactic acid bacteria and yeasts open up a fascinating world of flavour refinement for a variety of other foods in a natural way.


Dillon Organic make delicious Organic Keto breads made with a blend of flax, sunflower seeds, and caraway seeds for flavour. It comes as an unsliced half loaf and that gives you the freedom to choose which thickness you'd like to make your slice.
Great toasted or double toasted and made into an open sandwich. It is delicious tasting bread that helps keep you fuller for longer, and replaces the need to reach for a high carb loaf with a healthy, keto-based alternative.
It is:
● Organic
● Keto
● Gluten Free
● High Fibre
● Vegan
● High Omega 3
● Diabetic friendly
● Low sugar
Unlike many low carb breads, Dillon Organic never use ultra processed food ingredients such as additives,
thickeners or emulsifiers and stay away from added gluten and eggs. They recently launched delicious Gluten free sliced bread packed full of green olives and organic seeds including Sunflower, Flax, and pumpkin.

An outstanding example is the fermentation of legumes such as chickpeas, beans or peas. Due to their nutritional benefits legumes are used in many vegan protein-rich products in the food industry. However, the typical undesirable offflavours of legumes, which are perceived as unpleasant by many consumers, represent a challenge.
By using fermentation in combination with drying processes new aroma compounds of legumes can be created. This approach not only reduces specific aroma profiles but also has the potential to engender entirely new, distinctive ones. For example, if you compare the aroma profile of chickpea flour with dried chickpea sourdough, you will notice clear differences in the aroma profile. While chickpea flour has a slightly fishy flavour, dried chickpea sourdough is characterised by roasted, malty peanut flavours. This only describes one possible flavour adjustment of chickpea flour. Targeted fermentation, specially adapted to the individual raw material, can also bring out other flavours of the same flour. The same applies to other legumes.

These are also Gluten and dairy free, vegan, low carb and high fibre. The breads are available in H&B stores, Wholefoods Market, Planet Organic, Abel & Cole, Revital, independent health stores and Amazon. Wholesalers include: CLF, Suma, Essential, Hunts/Queenswood and Independent Irish Health foods.
Contact: Nick Bildner info@dillonorganic.co.uk www.dillonorganic.co.uk
It becomes clear that BÖCKER can use fermentation in a targeted manner and fulfil individual aroma requirements of customers in the food industry. In this way, an individual aroma profile for the selected product can be created together with the customer.
marketing@sauerteig.de

In this issue of Food & Drink Matters, we are pleased to feature Martins as our Artisan Handmade Pies Production Company of the Month

In the quaint town of Whitchurch in Shropshire, Martins is a small artisan producer known for creating premium handmade pies and ready meals using local fresh ingredients and crafted by the hands of founder and main piemaker David Martin.
David has been involved in the food industry ever since he left school. Whether it was working as a kitchen porter or college jobs in kitchen pubs and caravan parks, it’s safe to say David has had his finger in almost every pie when it comes to the restaurant and catering industry.
David has worked his way up from country kitchens to fine dining but his time spent in Michelin star restaurant kitchens where he was predominantly based on the pastry section, was where he learnt a lot of his craft. From developing his own style of food to learning how to put together taster menus, David learnt the ins and outs of how to run a successful kitchen.
“Good British classic cooking is what I am all about and what I am trained in. My mindset has always been to push innovation and to never fall short of using the highest-quality produce I can find. My times as senior development chef allowed me to be creative but to also hone in on my pastry techniques and skills, and that’s when I decided I wanted to have a go at making my own,” said David.
Like many of us, COVID-19 allowed us the time and space to channel our energy into new paths. David grabbed the opportunity to then develop his own pies and menus and started delivering them to local customers himself. This carried on for two years of which David was also working another full-time job at the same time.
Another leap of faith saw David bite the bullet and really give the business a go at getting off the ground once and for all. David managed to link up with Alternative Meats – a local supplier of premium wagyu beef, and this was when their award-winning flagship product the Wagyu Beef & Ale pie was born!


so much so, that last year was it was entered into the Great Taste Awards 2023. Available in perfect individual portions, this certainly has to come top trumps as one of Great Britain’s heartiest comfort foods.
Using a combination of pan seared beef shin, caramalised onions, mushrooms and Darwin’s Origin ale from Salopian Brewery all wrapped in handmade traditional pork lard shortcrust pastry, the moment the plate arrived in front of the judges, it was a guaranteed gold.
David commented, “We didn’t expect it at all, but lo and behold our product won and over 50 judges awarded it three stars! We were invited to London for the award ceremony at Battersea Art centre, which to our surprise we ended up being nominated for the Supreme Champion Award and ended up coming 10th out of nearly 15,000 other contestants!”
This was the turning point for Martins and a milestone for the company that really shot its popularity into existence. Since, the company has continued to grow with the Wagyu Beef & Ale pie still being its most popular & flagship product. Other pies included in its awardwinning range are Wagyu Beef & Stilton, Steak Peppercorn & Caramelised Onion, Three Cheese & Onion, Beef Bourguignon, Chilli Beef Con Carne, Sausage Bean & Cheese, Creamy Chicken Leek Bacon & Blue Cheese and many more.
“What began as a side hussle for roughly 18 months to two years on top of working 50 hour weeks is now my full-time business. Once the decision to go full-time was made, a plot came up in Whitchurch of which we managed to secure and that’s when Martins became a physical business with a face,” said David.
In a short space of time, Martins has become infamously known for its mouthwateringly good Wagyu Beef & Ale pie,


Having been open only a couple of months, the shop in Whitchurch also welcomes customers to come in and indulge in some coffee or baked goods. “We mainly work with wholesale independent businesses supplying farm shops, restaurants, other cafes but you can buy from us direct on our website as well as order in the café,” added David.
Recently, Martins also changed its product line from chilled to frozen to better cater to its customers and also to improve its own manufacturing quality. David has vast experience in this sector of the market as he also used to work at Oscar Mayor where he helped to develop and design chilled ready meals for some major supermarkets such as Co-op, Asda, Sainsbury’s, and Aldi.
David has put all this knowledge and expertise into Martins Ready Meals that are made with love and passion using only the highest-quality local ingredients with meat being sourced from within 10-15 miles and partnering with only local premium farms.
Sustainability is also at the forefront of Martins. Making every effort to reduce carbon footprint and ensure its packaging is as eco-friendly as viably possible, simple switches such as using foil trays and cardboard sleeves for its packaging is a great start. “We are on our way to making all our packaging 100% fully recyclable and are currently looking into other


branded and more eco-friendly packaging to keep our products chilled. Of course, as a small business we have our economic challenges but, in the future, we are keen to further streamline our business model to ensure we continue to focus on less is more, and by this, I mean, we may not have the largest range of products but the products we do have are of the highestquality therefore we can produce a much higher volume of the products people want. That then results in less food waste which is great too,” added David.
Martins also contributes monthly to the Hunger Charity UK. David explained, “For every single sale we make from retail to wholesale we donate one penny to the hunger charity UK. Currently, our total already stands at £47.25 after three months and will grow over the coming months. As a premium manufacturer we want to give back to those that really need it and we’re blown away by how fast it totals up and without knowing it every customer is helping make a change.”
Martins is currently in the process of finalising a new deal with a local supermarket which will be a game changer for its future, and, this is what David would like the business to capitalise more on up and down the UK. He said, “Of course, we want to grow but it must be sustainably and steadily. We don’t want to burn out to soon. We are looking to connect with new suppliers and brands and are always looking for ways to grow.”
If you’re interested in stocking Martins, get in touch below:
T 01948 838105 info@martinspies.co.uk www.martinspies.co.uk



The wind may blow and the rain may fall, but nothing dampened the spirits at Scotland’s Speciality Food & Drink Show which took place from 21-23 January 2024 at the SEC, Glasgow. Business was brisk over the three day Show with many exhibitors reporting a raft of new leads and orders made.
The overall mood of the Show was one of optimism as the quality of the retailers attending outweighed the expected reduction in footfall.
Neil Chalmers from Walkers Shortbread said, “It’s been wonderful to re-connect with our existing customers and to pick up quite a few new orders. It’s a vital Show for us and it’s been a great few days.”
Food and drink companies from across Scotland and beyond tempted buyers from farm shops, delis, hotels and tourist outlets to sample their produce. The three large regional stands from Orkney, East Lothian and Food from Argyll were particular hot spots, as was the Launch Gallery with its array of drinks, cocktails, chocolates and coffee.
Ben Dale from Cairn Lodge, part of the Westmorland Group, said, “This Show is the
Chocolate Tree have taken the Gold award for best confectionary product at this year’s Scotland’s Speciality Food Show in Glasgow. They were delighted to receive the award for their new Scottish themed chocolate bars which were officially launched at the show.
Chocolate Tree have created award winning organic craft chocolate since their beginning at music festivals in the summer of 2005. Since then, they have ran a successful café and shop in Edinburgh for a decade, and gone on to export their organic chocolate all over the world to independent wholesalers and retailers.

Chocolate Tree source all their organic cacao from South and Central America, ensuring a fair price is

paid to the cooperatives and smallholders. They take a down to earth but artisanal approach to chocolate making from cocoa mass and bean to bar, their range includes some single estate origin bars alongside some fun and nutritious bars with inclusions and toppings.
Everything they use in their factory is sourced with consideration for how it is produced, where it comes from, and if it is really needed in the first place. Their delicious chocolate is only made with simple and pure ingredients, and their packaging is biodegradable or from other sustainable and recyclable sources.
Find out more about Chocolate Tree at: www.choctree.co.uk / @ChocTreeScotland
Congratulations to The Moray Honey Company whose successful exhibit at the Scottish Trade Fair earlier this year spoke volumes about the quality of its products as it continues building on its early success.
The Moray Honey Company was established by Yogi who inherited three hives from her father in 2018. Taking on the family business, Yogi has really made it her own and alongside her daughter Thalia, they have both developed and built The Moray Honey Company into a fruitful business that remains true to their family vision and history whilst ensuring it continues its success for many generations to come.

Honey, and Scottish Heather Honey, they also make and sell their own preserves such as Chilli Jam, Quince Jelly, and Granny’s Secret Dressing. If these products aren’t enough, you’ll also find Scottish Tablet in two flavours: Vanilla and Scottish Heather Honey, as well as a range of small gifts such as lip balms, candles, and honey drizzle sticks.
Beyond the exceptional taste of its products, The Moray Honey Company delivers excellent customer service and can deliver products nationwide. Whether you’re a local supplier looking for stock, or a food enthusiast, Moray Honey offers homemade honey products to anyone seeking pure Scottish goodness.

best event of the buying calendar for food and drink by a mile. It is so nice to see so many producers who really know their products and are brimming with innovation.”
Best Product Awards were judged on Sunday morning by Catherine Cobb from Cobbs, Geraldine Bruce from Sainsbury’s, Linda McLean from Kintyre Larder and Jonathan Macdonald from Ox & Finch and Ka Pao restaurants.
Scotland’s Trade Fair Spring & Speciality Food & Drink Show 2025 returns next year at Glasgow’s SEC from 19-21 January 2025. Before then, Scotland’s Trade Fair Autumn 2024 is held at Glasgow’s SEC from 18-19 August 2024.
www.scotlandstradefairs.com

Founded in 2022, Three Robins is a new oat milk brand designed for families on a mission to make healthy, great-tasting oat milk products that kids, their parents and the planet will love.
Our award-winning original and flavoured oat milks are barista standard, low in sugar and fully fortified, and are perfect for the whole family from breakfast through to bedtime. They are designed for use in all hot and cold drinks, and the ideal all-rounders for busy cafes and restaurants or shops that attract families who are looking for healthier plant-based options that don’t compromise on flavour.
Look out for our innovative new Little Smoothies for kids that will be hitting shelves soon. They combine an oat milk base with real fruit and vegetable purees to make a delicious and healthy lunchbox treat or snack on the go for nursery and primary school age children. They are fully fortified and a source of fibre, calcium, vitamin D and B12. All of our products are ambient and made in the UK at BRC-certified manufacturers.
Based near Forres, North-East Scotland, The Moray Honey Company has diversified its range over the years and as well as stocking a mouth-wateringly range of honey products: Soft Set Honey, Raw
M 07727 148588
yogi@themorayhoneycompany.co.uk
https://themorayhoneycompany.co.uk
For more information on our range, including wholesale pricing, please contact us: T 0131 210 0397
karen@threerobins.co.uk
www.threerobins.co.uk
In this issue of Food & Drink Matters we are pleased to feature Conservas Pedro Luis as our Organic Preserves Company of the
Conservas Pedro Luis is a family business founded in 1988 that manufacture high-quality products with a strong commitment to the environment. Based in Lodosa, Navarra, the company floroushes off of the family spirit and love that was engrained into the business over 40 years ago by Lidia Antón Campo’s parents.

without good raw materials. Over time we have adapted our production process to incorporate technical resources that meet the highest quality of food safety standards as well as traceability, without losing sight of our roots and the principles of handmade production,” added Lidia.

“Our parents dedicated their lives to farming. It was at the end of the 60s when they began to pack the fruits that they collected from their own land: Piquillo Peppers from Lodosa (P.D.O) and Asparagus from Navarra (P.G.I).
“Today, we work extremely hard to ensure as much of the crops and the production process retains that personal stamp of the craftsman.

“We work closely with our support farmers from the bank of the Ebro River in Navarra. We plan and control the crops to ensure the most appropriated season for harvesting. Our seasonal products are manufactured right after harvesting, when they are the freshest and their flavour is at its best,” stated Lidia.
One of its newest additions is Natube – the best selection of fresh and seasonal ingredients for your baby. Using the finest ingredients combined with all the guarantees and experience of Conservas Pedro Luis, the range consists of various flavoured purees and creams that come in 230g glass jars.
“Our new range of baby food is made from the best selection of fresh and seasonal ingredients. We use absolutely no added sugar, salt, colouring agents, preservatives, gluten, starch, or any other additives.
“Vegetables, rice, legumes, cereals, fruit, fish, meat, and extra virgin olive oil are the foundation of the 9 recipes that come ready to eat and are ideal in providing a healthy and balanced diet to babies at any time and place,” said Lidia.
Pedro Luis takes its environmental responsibility very seriously and over the years has worked hard to ensure that sustainable farming methods remain throughout all its production.

philosophy regarding sustainability is that a sustainable food system means growing, producing, processing, packaging, distributing and consuming food without negatively impacting the planet. We want to provide access to safe, affordable, and nutritious food, and minimise food loss and food waste. We work together with reliable farmers from the Ribera del Ebro in Navarra and have a strict control of traceability from the point of origin to the ultimate destination.

“We also have an agreement for the integral management of the waste, and we are certified as a 100% zero discharge commitment entity. We have solar panels in both our premises and we have a water recirculation system that uses water more than once, after being renewed,” stated Lidia.

Care and attention is key when it comes to the production process and the company is proud to state that all its products and facilities are awarded with the IFS quality certification. The greens and vegetables: tomato, asparagus, peppers, artichokes, and lots more are always processed immediately after harvesting so that they retain all of their properties.
“All our products are made on our own premises. The raw materials come from local farmers who are committed to quality, food safety and the environment. We are aware that it is not possible to obtain a quality product
“All our products are made on our own premises. The raw materials come from local farmers who are committed to quality, food safety and the environment. Our business
info@conservaspedroluis.com
www.conservaspedroluis.com

Just one of the funny phrases our parents said when we were young, along with “I’ll give you a bike”, “don’t make me count to 3” and “If your friends jumped off a cliff would you follow?”
In among these though were some wise words. For example, “all things in moderation” and “people in the world are starving, eat your food”.
Sustainability is high on all our agendas. One definition of sustainability is “that which conserves an ecological balance by avoiding depletion of the Earth’s natural resources”.
What is your definition? Sustainability means different things to different people.
The most pressing problem for the world at the moment is global warming.
COP Summits are being held by the United Nations (UN) to ensure that countries take action to limit global warming to well below 2 degrees Celsius and ideally below 1.5 degrees.
At COP26 Sir David Attenborough said that, “We are the greatest problem-solvers that have ever existed on Earth. Humans have the capacity to solve the problems that have led us to this point.”
So, what do we need to do?
According to the UN, the top actions we can take to help limit climate change are:
● Save energy and consider changing to renewable sources like wind or solar.
● Consider how you travel to reduce the amount of fuel used.
● Eat more vegetables – plantbased foods generally result in fewer greenhouse gas emissions and require less energy, land, and water.
● Reduce the number of flights.
● Throw away less food.
● Reduce, reuse, repair, and recycle, especially electronics, clothes, and plastic.
So, fuel, food, and saving/ re-using resources. As our parents said – “All things in moderation.”
As a consumer, do we really need fruit and vegetables that have been chopped up for us and packed in plastic when most have their inbuilt packaging, and we have knives at home? But there are many foods that without technical plastic packaging would never reach our supermarket shelves and the much-reduced shelf life would mean we would have to shop every other day at a corner
shop and eat what we bought almost immediately. Our whole way of life would have to change!
At the moment, the UK produces the highest amount of food waste in Europe.
Over a third of all food produced globally goes to waste.
The United Kingdom throws away around 9.5 million tonnes of food waste in a single year – even though 8.4 million people in the UK are in food poverty. Just look at the increasing use of foodbanks. As our parents said, “People in the world are starving.”
Billions of pounds are wasted each year when food is disposed of unnecessarily.
The vast majority of food waste ends up in a landfill site. Food items degrade naturally over time, which contributes heavily to global warming. This is because methane gas is produced as it breaks down. Methane is 25 times more harmful than carbon dioxide because it can trap heat within the atmosphere.



Packaging helps reduce food waste by preserving and protecting the product.
We are a flexible packaging supplier, so we would defend plastic, wouldn’t we?
Endless research has been done (and is being done) into the efficiency of different packaging materials. Perhaps the most significant one was by McKinsey Co in 2022. This focussed on total greenhouse gas emissions of plastic vs alternative materials. The materials included for comparison were Paper/Board/ Glass/Aluminium for various applications.
While commenting that “No single packaging substrate is an absolute leader across every aspect of packaging sustainability,” they found that in 13 of 14 applications they examined, greenhouse gas emission savings ranged from 10-90% when using plastics, rather than an alternative material.
We talk to our customers to understand what they are
trying to achieve and offer different solutions. Sometimes that involves plastic and sometimes it doesn’t. We offer one of the widest portfolios of different sustainable materials from recyclable paper, to single polymer solutions and carbon-neutral films.
We offer free no-obligation sustainability packaging audits. These audits offer a comprehensive assessment of a company’s packaging practices, materials, and processes to identify opportunities for improvement in environmental and overall sustainability. Undertaken by a Packaging Engineer and Packaging Technologist, these audits review our customers’ packing lines including pack design, forming, machine type, running speed, film utilisation, end-of-line, and transit packaging.
Our audits have proven to be extremely successful, with customers receiving £2.5 million in cost savings in just one year.
Not only do we have a climate-positive workforce, but we were also the first flexible packaging company to become a carbonneutral business.
Get in touch with our team and see how, together, we can ensure the future is flexible, sustainable, and undeniably green.
Contact
T 01274 685566
joanna@nationalflexible.net
www.nationalflexible.co.uk

The last ten years have seen a renaissance in food delivery packaging, with changing consumer habits, environmental concerns, breakthroughs in technology and the growth of online shopping, more companies are looking to find the right solution for their products.
With several options now to choose from, and sustainability the main packaging goal in 2024, how do you know which solution truly meets your needs?
When considering insulated packaging for food, having the right information to hand is crucial to finding the right solution. Your transit time, delivery method, sizing, production protocols… even the weather, all have a real impact on what you can achieve.
These details are small building blocks which are used to tailor a
solution that performs perfectly for your specific needs. But this need not be complicated, Woolcool have a team of experts on hand who do this part for you, to provide a simple, efficient solution, which balances the use materials to your sustainability goals.
With packaging made from nature’s smart fibre, 100% pure sheep’s wool, there’s never any need to compromise on sustainability or performance, Woolcool delivers both!
“We handle the complex part of the equation for you. Sometimes that can include testing and refining the correct combination of components and materials to optimise your passive packaging solution,” said Josie Morris MBE, Managing Director, Woolcool®
T 01785 262030 sales@woolcool.com www.woolcool.com
kp (Klöckner Pentaplast), global leader in rigid and flexible packaging and specialty film solutions, is proud of the success of its recycled coastal plastics initiative.
Partnering with the Keep Sea Blue organisation, kp plays its part in closing the loop on plastic waste through the use of Recycled Coastal Plastics®, a certified post-consumer recycled raw material recovered from within 10km of the coastline in the Mediterranean basin.

In 2023, kp used more than 800 tonnes of recycled PET waste collected through this initiative to create new packaging. It is the equivalent of reusing 14 million PET bottles and underlines kp’s aim of promoting environmental stewardship and sustainably designed packaging solutions.
Keep Sea Blue’s Blockchain platform, powered by Oracle technology, enables the team at kp to conduct rigorous quality checks, verifying the origin, date, and location of plastic collection. The recycling process adheres to BRC, ISO 9001, and RecyClass certifications.
With over two decades of expertise in manufacturing high-quality products from post-consumer recycled PET, kp ensures the highest standards of food safety through the production of quality packaging solutions. Packaging using Recycled Coastal Plastics® material is produced at multiple kp production sites across Europe and supplied to customers in Germany, Italy, Portugal, Turkey, and the UK.
To drive greater consumer awareness, kp has also developed a dedicated logo that customers can use on the packaging to signify the use of recycled coastal plastics.
To learn more about kp’s use of Recycled Coastal Plastics®, please visit: www.kpfilms.com/en/food-packaging/ Recycled-Coastal-Plastics/


 Gillian Harding-Moore Director – Marketing
Gillian Harding-Moore Director – Marketing


The first Quantex pump was invented by Quantex Founder, Dr Paul Pankhurst, to create a less expensive, more accurate alternative to a peristaltic pump. Several years of R&D and customer collaborations, led to the successful development of several off-the-shelf, recyclable pumps with varying flow-rate ranges. In June 2021, Quantex was acquired by PSG, an operating company of Dover Corporation and now sits alongside 14 other pump and flow measurement brands.

Since the acquisition, Quantex has moved its headquarters to Duisburg, Germany where it benefits from the established resources and clean room facilities already in place for other PSG brands: PSG Biotech Quattroflow, Almatec, and Hydro. Quantex’s London office and dedicated manufacturing plant in High Wycombe are still in operation.
“Quantex is the leading provider of recyclable pump technology, where, instead of the pump being a part of the fixed equipment, it is attached directly to the liquid packaging – similar to the way a tap is already connected to a bag in box of wine. But

instead of pressing the tap and allowing liquid to dribble out using gravity, the pump is clipped into a motor drive in the fixed equipment, and the product is dispensed accurately, at a range of precision flow rates suitable for all kinds of liquids. When the product supply is finished, you simply replace the bag and pump with a new bag and pump,” stated Gillian Harding-Moore, Director – Marketing.
Quantex’s system is extremely hygienic and requires no costly cleaning or maintenance. The Quantex pumps also maintain vacuum capability which equips them with the ability to handle high viscosities such as mayonnaise, hair conditioner, or glue, and can evacuate the bag by up to 98%.
“The pumps can also reverse cycle which is widely used for cleaning the nozzle at the end of each dispense by sucking the product back into the pump. Another very exciting capability is its in-pump dilution option, where it can pump highratio concentrates, and accurately mix them with water at the point of dispense. This takes water out of the distribution channel, saving the customer both money and carbon emissions from shipping their products around the world,” added Gillian.
With the drive to save single-use plastic waste, the wealth of benefits of using Quantex pumps has been recognised by UK and European supermarkets, who have been attempting to trial refill stations, where consumers bring their reusable bottles to refill in stores instead of using single use pre-packaged goods. Dispensing liquids has been proving to be too expensive and labour intensive for shop-floor staff.
“Quantex technology provides the key enabler for scaling up refill in supermarkets, with a low maintenance, low cost and flexible solution that can be standardised for dispensing virtually any fluid. Quantex has worked with several refill equipment manufacturers, who have designed their next generation of dispensers around the Quantex


system.” Gillian continued, “Early prototypes have demonstrated that product replenishment can be up to 75% faster, with no cleaning or maintenance, and no drips that can cause dangerous slip hazards in supermarket isles. The aim is to provide a better refill experience for consumers and therefore, encourage more refill adoption. The first machine is planned to be in British retail trials in 2024. It is an exciting market to be in, as it is just the beginning of a big change to the way we shop, and Quantex is is one of the key enablers of the movement.”
As the company looks ahead, in addition to Refill, Quantex is moving into the Biopharma market, aligning with other Dover brands; PSG Biotech and Quattroflow®. Gillian added, “Since Quattroflow pumps are the most trusted and widely used pump brand in the biotech market, the Quattroflow team have used their extensive experience to suitably develop the Quantex technology. By adding these single-use microdosing rotary pumps to the PSG Biotech portfolio, we will be strengthening our PSG Biotech offering, broadening our range of pump and flow measurement solutions, not only from upstream and downstream applications but to cell and gene therapy and lower-flow laboratory applications.


In this issue of Food & Drink Matters, we are featuring SumUp with its innovative kitchen technology system for busy food and restaurant outlets everywhere

The SumUp kiosk is fully integrated to the kitchen display system (KDS) as well as the point of sale (POS) system. This digital device streams all orders, whether placed on the kiosk, counter or via the ordering app directly onto the KDS tablet in the kitchen, allowing for a one-stop shop for all kitchen and serving staff. If you want your kitchen to get ahead of the curve and offer optimised customer service, it’s time to look at investing in this unique ‘plug & play’ product today.
There are multiple benefits to using this innovative approach:
● Streamlined ordering system – staff won’t have to deal with receipts from multiple sources, saving precious time to focus on order preparation and customer service
● Reduced errors in orders – thanks to automatic order prioritisation and clear instructions on special requests and add-ons
● Customer base – quick-service restaurants and cafés using multiple ordering channels and with high footfall at peak times, require streamlined operations.
The SumUp Kiosk is the only ‘plug & play’ product on the market and with a simple set-up and UK customer service support,
your only regret will be that you didn’t invest earlier.
SumUp is the market-leading, global fintech company that supports businesses with a wide range of expert products, including: card readers, point of sale solutions, self-service kiosks, Tap to Pay on iPhone, business accounts, invoices, payment links & online store.
Established in 2012, SumUp is focused on helping independent businesses grow through cost-effective products, support with customer relations and financial monitoring. With four million businesses using their services, SumUp has been at the forefront of the global financial empowerment of smaller businesses for the last twelve years.
The number of quick-service businesses have increased in recent times, with 44.8 thousand takeaway and fast-food restaurants alone in 2023, an increase of 2,600 since 2022 (source: Statista.com). Since the COVID pandemic, there has been a growing appetite for the ease and convenience of quick-service food outlets and with many now offering food from around the world, customers can order at the touch of a button.
SumUp is now supporting these quickservice businesses with a complete package that equips them with the tools they need to


The quick-service package will allow businesses to save on hardware costs, monthly fees and optimise the flow of kitchen to customer operations. The package includes the following:
● Point of sale Pro – acting as a central hub, all orders can be managed, stock checked and menu changed with just a few clicks.
● SumUp Kiosk – a self-service ordering terminal with integrated card reader. Proven to reduce queues by up to 50% and automatically upsells orders by up to 35%, suggesting add-on items at checkout.
● Kitchen display screen (KDS) – all orders from the kiosk and POS system are organised on your display in real time, streamlining communication between your kitchen and counter.
● Solo card reader – designed as a portable handy device to accept card and contactless payments via unlimited, builtin data or Wi-Fi connectivity.
Businesses can purchase the quick-service package for a one-time reduced hardware cost of £599 and a £59 monthly fixed software fee. There is a reduced transaction fee of 0.99% upon accepting payments via SumUp card readers, including a guarantee that your fee will never increase. With dedicated customer service support, SumUp will help businesses migrate from current providers to the quick-service package. With UK-based support available via phone and email, customers can access support anytime they need it.
Meet SumUp at: London Coffee Festival 2024: 11-14 April, Truman Brewery and Hotel, Restaurant & Catering (HRC) 2024: 25-27 March. ExCeL, London.
To book a demonstration today, or to find out more from the in-house sales team, please call the in-house sales team on +44 (0)20 3936 1981 or learn more via this link: www.sumup.co.uk/qsr



The healing power of food was noted by The Father of Medicine: Hippocrates back in 400 BC who advised about the nutritional benefits of healthy food, “Let medicine be thy food and let food be thy medicine.”
We know there is a direct link between the food we eat and our mental and physical wellbeing. Heathy nutrition can affect everything from immune systems, brain cells, through to increased fertility and increased life expectancy.
The Multi-Award-Winning College of Naturopathic Medicine (CNM) stands on the shoulders of Hippocrates and runs an extensive training provision of excellent natural therapies. With a focus on clinical application and practice, students can study short courses, diplomas, degrees and post-graduate qualifications across a wide range of subjects including: Nutrition, Natural Chef and Vegan Natural Chef.

Founded in 1998 by celebrated Naturopath Hermann Keppler, CNM has grown at a phenomenal rate over the last twenty-six years, with ten training colleges across the UK and Ireland and plans to expand into Dubai, The United Arab Emirates, Gulf States, Italy, Canada and the USA throughout 2024.


The College has won the prestigious IHCAN Education Award for Best College consecutively over a three year period from 2021 to 2023 and 80% of CNM graduates are working as practitioners or running their own businesses as Marketing Manager, Caterina Angelici, outlines, “Our nutritional and chef graduates are working across an eclectic spectrum such as: retreat chefs, restaurant chefs, personal chefs, recipe developers, cook book authors, health coaches and as deli, café or restaurant owners. The Alumni section on our website promotes the careers of our graduates and we are proud of their collective success. Such is the power of nutrition and healthy food, that we are attracting NHS staff who are curious about the link between food and health, practising holistic practitioners who want to further their knowledge about nutrition, through to students in their 40s and 50s wishing to make a mid-life career change.”

vegan diets, we offer the practical Vegan Natural Chef Diploma alongside our Natural Chef Diploma. Both courses last 9-12 months, with 840 hours of carefully chosen lessons including 100 hours internship in an external kitchen, with options to study online. Students have practical cooking lessons and learn how to successfully run businesses, alongside understanding the therapeutic power of food.”
The Vegconomist has reported that the UK vegan food market rate has a growth rate of 9.58% and it is predicted that by 2025 there will be 15 million meatfree UK citizens (including vegetarians and pescatarians).
To learn more about the award-winning CNM courses, see the websites below:
www.naturalchef.com/
vegan-natural-chef-diploma-course
www.naturalchef.com/cooking-course
www.naturopathy-uk.com
The new BCS (Hons) Nutritional Therapy started in January this year and offers classes in-person in London and online for international students. It is validated by The University of Buckingham, accredited by GNC, ANP and NNA and involves 500 clinical hours of study. Students learn sequentially about pathology, how the body works, the basics of naturopathic nutrition and herbal medicine, through to naturopathic diagnostic tools, specialist fields like paediatrics and fertility and will have the opportunity to start working as a practitioner under clinical supervision during the course.
“The BSC is offered as a part or full-time course to fit around the lives of our students. With the additional rise in the popularity of
www.naturopathy-uk.com/events
www.naturalchef.com/events-and-workshops

In this issue of Food & Drink Matters, we are pleased to feature Sallaku Oil as our Premium Extra Olive Oil Company of the Month

Sallaku Oil derives from the lush groves of Sallaku Farm, an ancestral land that has been in the family for the past three generations. Founded by Rozetta Sallaku Domi, Director of Sallaku Oil, Sallaku Farm Limited was established in 2021 in order to sell the olive oil generated from the farm here in the UK.
“The olives are harvested on our family farm in the Durres region of Albania. The olives are grown using natural, organic fertiliser and the land has been certified as organic. The olives are cold pressed at a local mill. The olive oil is then sent via road transportation in sterilised, stainless-steel containers to the UK,” said Rozetta.
From a small business unit in New Malden, the oil is then bottled, packed, labelled, sorted and distributed to customers around the UK. With a commitment to quality and sustainability, each drop of Sallaku Oil carries the essence of family heritage and the pure goodness of nature. “Sallaku Farm is always looking to support sustainability and reduce our carbon footprint starting with the manner in which we fertilise the land. We use locally sourced natural fertilisers as well as local labour and make use of a local olive press,” added Rozetta.
South African, Pakistani, Albanian and English who have all supported me on my journey so far. It’s been a real international effort and I am extremely grateful to all of them,” stated Rozetta.
Sallaku Oil has captured the tastebuds of many food enthusiasts, in particularly at the BBC Good Food Show and the Fine Food Show, where the product really stood out from the crowd and had visitors commenting on how they could really taste the tradition and passion in every bottle!

Sallaku Oil believes strongly in offering equal opportunities and celebrates diversity. “We pay fair wages to local workers, and I have a very diverse group of friends – Iranian, Uzbek,
“My true passion in life is food and my ultimate dream is to share the joy and rich, earthy flavours of natural Albanian olive oil with everybody.”
A quote taken from Rozetta whose love and passion for the brand is evident in the speed of which the company is growing. Looking to always stay one step ahead of her competitors, Rozetta is always forward-thinking in her planning and has some great ideas for the company over the next few years.
She commented, “I am investigating the viability of infused olive oils, and in the future, I would like to add other artisan food produce from Albania to my product line.
“In 2021 we harvested 600 x 500ml bottles, in 2022 it grew to 900 x 500ml bottles, and in 2023 we reached 1,200 x 500ml bottles. In 2024, I hope to further increase this amount again!

“I am also looking into sourcing additional organic extra virgin olive oil of a similar quality from other local groves in Durres. At the same time I want to help other farms in Durres to improve their land to the same standard.”
After a recent relaunch of its website as well, Sallaku Oil has already hit the ground running in 2024. With plans to also sell internationally as well as in the UK, Rozetta will also continue to push her products into well-known restaurants where she already has a sturdy relationship with Bibendum, head chef Francesco Dibenedetto in London.
T 02036 741936 info@sallakuoil.com
www.sallakuoil.com
www.instagram.com/sallakuoliveoil

In recent years, the popularity of functional drinks has surged, fuelled by a growing consumer interest in health and well-being. These beverages, labelled as ‘functional’, go beyond basic nutrition by providing additional health benefits with the inclusion of vitamins, minerals, adaptogens and other beneficial ingredients.

without the hassle of consuming multiple pills and powders. These beverages provide a wide array of health benefits and are increasingly becoming a preferred choice for those seeking wellness, lower calorie options, or embracing sobriety. They enable people to maintain a balanced social life without compromising their health or budget.
One notable brand making waves in this space is Jamu Wild Water, a company based in Devon founded by Tahi and Patrick Grant-Sturgis. Their natural, sugar-free sparkling waters are carefully crafted with the microbiome in mind. Each can contains 100% of the daily prebiotic fibre requirement along with a blend of botanicals such as dandelion, marshmallow root, and elderberry, creating a refreshing and delightful way to hydrate while promoting a healthy gut. The success of their ‘wild water’ range is evident through the numerous awards they have received, including a prestigious gold award at Nourish 2023, the UK’s leading health food awards.
Functional drinks offer a convenient and enjoyable way for individuals to incorporate essential nutrients into their daily routines
As consumers continue to prioritise their wellbeing, the demand for functional beverages is projected to grow, with innovative brands leading the way towards a healthier future. This trend signifies a broader societal shift towards proactive health management, with more individuals embracing the idea of ‘food as medicine’. Brands like Jamu Wild Water exemplify this trend by offering natural ingredients and healthful properties in their products, ensuring that consumers not only enjoy the taste but also receive tangible health benefits. The rising presence of functional drinks in various establishments and on menus underscores their appeal as a healthier alternative in today’s health-conscious society. The evolving landscape of functional beverages reflects a changing attitude towards holistic health and wellness, highlighting a shift towards

proactive health choices and the power of functional drinks in promoting a healthier lifestyle.
To find out more about Jamu Wild Water, check out the website at: www.jamuwildwater.co.uk
Distributors include:
● Inn-Express
● Dundais
● Diverse Fine Food
● Delicious Ideas
● CLF

The Kraken Rum has unleashed a new limited edition that tells the tale of a narrow escape from the clutches of the Beast, a feat of survival as elusive as the edition itself.
First-hand accounts with the Beast are almost unheard of. But in the darkest corners of the ocean, forgotten tales of escape are rising to the surface, stories that are so shocking they have quickly become legend. Kraken’s Legendary Survivor Series brings to life these gripping stories, each illustrated by a different artist with a unique, eye-catching style.
The series begins with the perilous tale of the brave lighthouse keeper, illustrated by Justin Estcourt. The bottle captures the Kraken’s devastating attack in spinechilling detail. Rumour has it that the lighthouse keeper battled with the Beast from his tower as its tentacles attacked his home, but curious Kraken fans will

have to study the bottle to discover how he made his escape.
With a bespoke whitegloss finish, a foiled logo and a fearsome design, this bottle will sit as a terrifying collectable on any shelf. But collectors must move quickly. For fear of rousing the Beast’s anger, only a limited number of bottles have been released and are available on Amazon and other speciality retailers from February 26th.
To get your tentacles on the first bottle of The Kraken Black Spiced Rum Legendary Survivor Series: The Lighthouse Keeper Limited Edition head to Amazon – available now and priced at £36.50.
The Limited Edition bottle can also be found at The Beast’s online portal, The League of Darkness: www.theleagueofdarkness.co.uk

Mochanera n°0 marks a revolution in the world of coffee liqueurs. It is the first product of its kind to successfully integrate CO2 decaffeination, reducing the caffeine content to an exceptionally low level of 0.016 g/L, well below European standards.

culmination of a quest for perfection and authenticity. It is the fruit of collaboration between the master brewers of Secret Arts of Spirits and coffee experts, uniting their expertise to create an extraordinary liqueur.
Innovation and Quality – The Mochanera range, from n°0 to n°4, offers a palette of flavours and intensities, each number reflecting the richness of diverse origins and a unique manufacturing process. Coffee tree honey, added to Mochanera n°0, enriches the liqueur with unparalleled sweetness and complexity.
Responding to Market Demand –Mochanera n°0 was designed to meet the growing market demand for decaffeinated coffees. Its unique taste profile makes it ideal for pure consumption or as a key ingredient in innovative cocktails.
History and Creativity – Inspired by the discovery of ancient coffee beans in a French barn, Mochanera is the
Commitment to Excellence – Every step of creating Mochanera demonstrates our commitment to excellence and quality. From selecting coffee beans to the decaffeination process, and the careful addition of coffee tree honey, each element contributes to the unique experience offered by Mochanera.
The Complete Range – Also discover Mochanera n°1 from Brazil, n°2 from Colombia, n°3 from the Dominican Republic, and n°4 from India, each offering distinct aromatic profiles for a taste journey around the world.
To discover the magic of Mochanera and its impact on the world of decaffeinated coffees and cocktails, contact Arthur CHAKHOIAN at: a.chakhoian@sas-spirits.com or call +33650101173.
Herefordshire independent cider makers, Celtic Marches, has rehomed the award-winning collection of Abrahalls cider in new designs, created to reflect the delicate quality and exceptional flavour profile of the cider. Premiumisation has been driving category growth across the board for drinks in recent years, and 47% of British consumers now agree that high-quality products or ingredients are worth paying more for*. With a new design, Celtic Marches has reimagined Abrahalls’ labels to help consumers identify these releases as premium, cider options with a renewed focus on provenance, taste and quality ingredients.
apples that are all tested and tasted before being crafted into cider. Focusing on quality over seasonal flavours, Abrahalls can be enjoyed all year round, tapping into the growing trend for cider throughout all seasons, with 83% of cider drinkers now open to consuming cider in the winter**.

While the number of British farmers is dropping year on year, the Celtic Marches team continues to preserve an important part of British agriculture with 200 hundred acres of commercial cider apple orchards. The new Abrahall labels have been designed to proudly share this provenance and passion for farming, encouraging conscious consumers to support independent farming producers.
A collection of three premium ciders, Abrahalls Dry Cider 6%, Medium Cider 6% and Vintage Cider 6%, Abrahalls was designed for the discerning cider drinker, who enjoys gastronomic adventures and quality food and drink pairings. Made from pip to bottle at the family farm in Herefordshire, with premium cider
The Abrahalls Collection is available now from: www.CelticMarches.com –RRP £2.49-2.79 per 500ml bottle.
*Mintel UK British Lifestyles Market Report, September 2023.
**Heineken UK Cider Report, December 2023.

Premium tasting coffee is a must for coffee outlets up and down the land but as all insiders know, great coffee comes from the best roasted coffee beans, the best coffee machines on the market but at its core, it must be great tasting water. Using a water filtration system is a surefire way to keep baristas and customers happy, along with preventing unwanted downtime. But what if it was also designed to help companies meet sustainability targets?
European WaterCare is the UK’s leading independent manufacturer and supplier of water filters, softeners and RO systems. They use their in-house laboratory and R&D centre to design environmentally-friendly cartridge filters.
The Harlow-based water expert is a proud Made in Britain company and is fast becoming an international sensation. Established in 1995 by Tony Rudman and Kit Free, the team prides itself on its premium range of water filters


for ice machines, speciality coffee, hot drinks vending, water boilers, water coolers and cold drinks post mix for the coffee and vending sector.
Although historically known for the iX filters and Calcium Treatment Units (CTUs), the full range of water treatment equipment includes softeners, combi pumps and reverse osmosis units, as well as bespoke set ups. A nationwide, fully trained service department are also on call.
The eco-friendly 100% recyclable iX cartridge filter is already the first of its kind, exclusively manufactured in Britain, with insert refill technology. No strangers to sustainable practices, European WaterCare have actively decreased plastic landfill in the water treatment sector by recycling hundreds of tonnes of filters annually, not only through recycling their own filters, but their competitors filters too.
“We have been working on our new filter range for a couple of years now, it is totally recyclable and when showcased, will be a new market innovation. Watch this space for more details!” explained Philip Rudman, Marketing Manager.
The range of existing iX filters offer the best price per litre on the market, saving up to 50% off filter costs and the iXwater quick release head has optional quick shut-off valves and digital flow meter to see how much water has been filtered (for accurate filter changes).
The variable blend head for coffee applications is designed to allow partial untreated water back into the water supply, for optimised coffee extraction and taste.
The ecofilterion removes limescale and dramatically improves water quality for espresso coffee machines & bean to cup systems, whereas the ecofiltervend works as a high-volume scale inhibitor for protecting vending machines, water boilers and beverage equipment.
Catch European WaterCare at The London Coffee Festival 2024: 11-14 April and The Glasgow Coffee Festival 2024: 11-12 May.
For more information on all products, please see the website below:
T +44 (0)1279 780250 info@watercare.co.uk www.watercare.co.uk


In this issue of Food & Drink Matters, we are pleased to feature The Sweet Scotch Egg Company as our Indulgent Confectionary Company of the Month
Fresh off the back of its first ever exhibition AND official launch at the BBC Good Food Show back in November 2023, The Sweet Scotch Egg Company offers exactly what you might be imagining and more! Think of a scotch egg, now change the breadcrumbs for biscuit, sausage meat for cookie dough, and chicken egg for a chocolate centre!
This mind-boggling concept shouldn’t work, but it does! Food enthusiasts went crazy for these at the food show which has become the ultimate platform for showcasing new products and launching new brands.
Let us indulge your imagination and dismantle what the sweet scotch eggs are actually made of. Take the Mini Gooey Caramel one for example: at the core of the egg is a gooey caramel centre that comes enrobed in a hard-set chocolate coating. This is then wrapped with a thick layer of crumbly cookie dough, encased with a milk chocolate crust and then finally, perfected with a set caramel drizzle on top. Other flavours include Caramelised Biscuit, Cookies and Cream, Caramel Crisp, Lemon Meringue, Black Forest, Raspberry and White Chocolate, Peanut Butter, and Hazelnut Praline.
These are available as individual favours named ‘The Big One’ or in an egg selection box as smaller bite sized pieces where for £15.00 you will receive a selection of their best-selling flavours, presented as 9 bitesize portions of Caramel Crisp, Milk Chocolate, Cookies and Cream, Caramelised Biscuit, and Lemon Meringue. And, if you really are addicted, there is also two subscription box services available. Choose from a 6 month or a 12month subscription and enjoy their egg of the month, delivered directly to your door! Prices starting from £30.00 p/6 months.


large ones to try, loved them! Then bought a couple of boxes for Christmas presents, one box was eaten as soon as we got home.”
Each round treat is truly decadent and flawless in appearance, and foodies up and down the country cannot get enough!
Just some customer reviews include: “These eggs are absolutely amazing. Just enough balance between sharp and sweet, crunchy and gooey.”
“Originally bought
The Sweet Scotch Egg Company was established by Zoe Konopka, owner of Heavenly Baking Ltd who opened their Coffee Shop & Tea Rooms based in Walsall Garden Centre, Walsall. The idea for the company came back in 2021 when she trialled the products at Heavenly Baking first before bringing the idea to life. After many rave reviews and requests to bring the product to the forefront of the food industry, Zoe took a leap of faith and since being accepted as an exhibitor at the BBC Good Food Show at the NEC in November 2023, The Sweet Scotch Egg Company has truly captured the attention of the foodie nation.
The Sweet Scotch Egg Company mainly works within the hospitality and retail sector, and if you’re a wholesaler looking to stock these products, they have proved extremely popular among customers looking for that uniquely different but extremely tasty alternative to a regular box of chocolates or bespoke cookies.


Of course, it is still early days for the company but Zoe has big plans for the next one to five years’ time.
“Firstly, we are extremely grateful to every single customer that has purchased and enjoyed our sweet scotch eggs. The response to the launch has been incredible. It is only early days yet but looking forward I will continue innovating and developing new recipes and products with the aim to maybe collaborate with other local garden centres, farm shops, and gift providers. To bring a new product line in the near future would be fantastic! For the next two years, however, we will continue to focus on increasing our number of stockists following our launch at the BBC Good Food Show in November 2023.”
Zoe has worked extremely hard to get not one, but both her businesses off the ground and is a striking role model for those who one day too may have aspirations to have their own company.
That being said, The Scotch Egg Company has opened its doors and partnered with The Hive College, a SEN college to provide work placements for students who are seeking to get into the hospitality and retail sectors. Zoe has been so impressed with the students; she has since offered employment to two students from the SEN college following their successful placements.
Zoe’s business practices demonstrate commitment to both the community and her future workforce. Encouraging others at a young age to believe in their potential, develop essential skills and take advantage of networking opportunities is also a great way to get the name of a new business out there. People talk, and word of mouth still holds its own as one of the most successful and powerful forms of marketing.

Here at Food & Drink Matters
we get extremely excited when we see start-up companies like The Sweet Scotch Egg Company offering such an opportunity to individuals that not only has knock on benefits to the business itself but also enriches the lives of those around them.
We have no doubt The Sweet Scotch Egg Company has a big future, and we can’t wait to see what comes next.
For more information or if you’re interested in becoming a stockist, see below: hello@thesweetscotcheggco.co.uk www.thesweetscotcheggco.co.uk










Brewed
Buy
Deliver
















